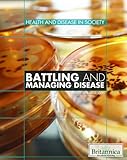
Cover image

Battling and managing disease / edited by Kara Rogers 6
By: 4 0 16 [, ] | [, ] |
Contributor(s): 5 6 [] |
Language: Unknown language code Summary language: Unknown language code Original language: Unknown language code Series: ; Health and disease in societyNew York : Britannica Educational Publishing in association with Rosen Educational Services, [2011];copyright 201146Edition: Description: 24 cm. xvii, 205 pages : illustrations, mapContent type: text Media type: 2 Carrier type: volumeISBN: 9781615303212 (hardcover : alkaline paper)ISSN: 2Other title: 6 []Uniform titles: | | Subject(s): -- 2 -- 0 -- -- | -- 2 -- 0 -- 6 -- | 2 0 -- | -- -- 20 -- | | -- -- history. Public health;Medicine, Popular.;Delivery of Health Care.;Disease;Cross-Cultural Comparison.;Developed Countries.;Developing Countries.;Socioeconomic Factors.;Public health.;Popular medicine. -- -- -- Popular works | -- -- -- 20 -- --Genre/Form: -- 2 -- Additional physical formats: DDC classification: | LOC classification: | Ref RA431 | .B388 20112Other classification:| Item type | Current location | Home library | Collection | Call number | Status | Date due | Barcode | Item holds |
|---|---|---|---|---|---|---|---|---|
| Book | PLM | PLM Health Sciences Library | Health Sciences-Reserved | Ref RA431 .B388 2011 (Browse shelf) | Available | H36284 |
Browsing PLM Shelves , Shelving location: Health Sciences Library , Collection code: Health Sciences-Reserved Close shelf browser
|
|
|
|
|
|
No cover image available | ||
| Ref RA1155 .F674 2006 Forensic nursing : a handbook for practice / | Ref RA1242.M34 .I584 1990 Toxic marine phytoplankton : proceedings of the Fourth International Conference on Toxic Marine Phytoplankton, held June 26-30 in Lund, Sweden / | Ref RA427 .M36 1992 On being in charge : a guide to management in primary health care / | Ref RA431 .B388 2011 Battling and managing disease / | Ref RA440 .C666 2003 Community health education methods : a practical guide / | Ref RA440 .C666 2009 Community health education methods : a practical guide / | Ref RA440 .U59 1997 An introductory study guide to public health and epidemiology / |
56
Includes bibliographical references (p. [196]-199) and index.
5
An exploration of the public health and disease that provides information on the history of public health, international organizations, financial and legal aspects of health care, noncommunicable and communicable diseases, research, treatments, and more.
Young Adult;Young Adult Follett Library Resources
5
There are no comments for this item.